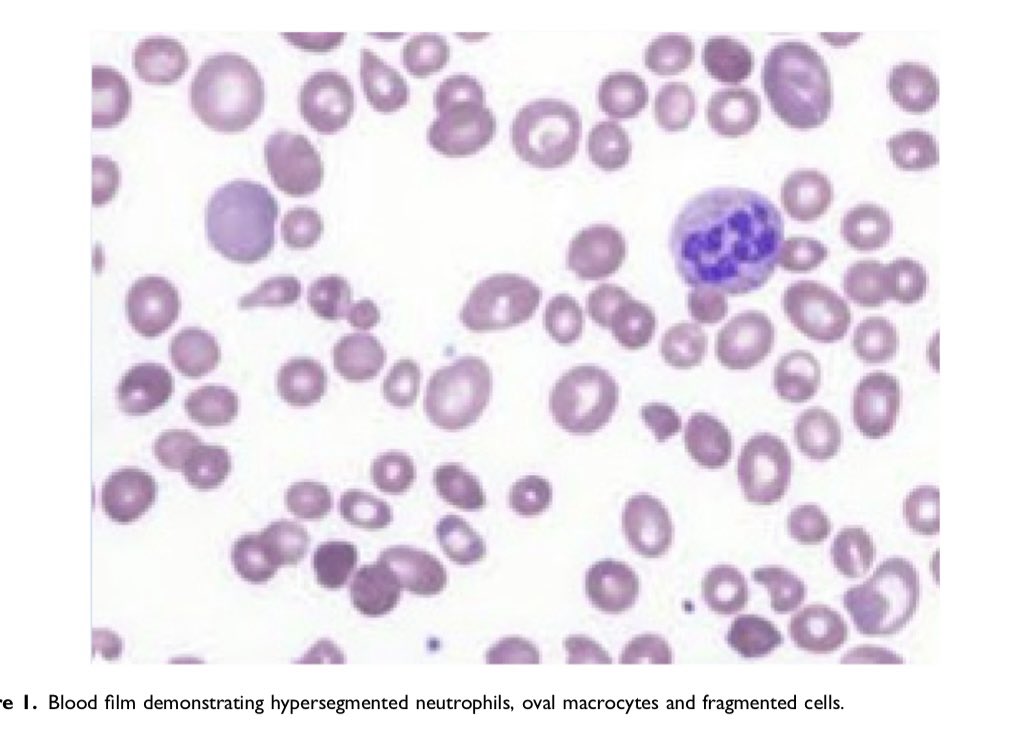
OBMedicine's tweet image. New online!
“Haematinic deficiency in pregnancy: another HELLP mimic”
by @drlaurengreen @obstetricmedic et al

journals.sagepub.com/doi/full/10.11…

ObsMedEd
@ObsMedEd
Obstetric Medicine education for everyone. Webinars, podcasts and more...
You might like
SO excited about the next webinar. Free to join. All welcome. 15.10.20, 7-8.30pm (BST). Obstetric Medicine: a global perspective 🌎🌍🌏🌎🌍🌏🌎🌍🌏 Thanks, as always, to @M0MSuk for supporting this venture.

We now have an Impact Factor! For 2022 (based on articles published 2020 & 2021) = 👉 0.7 👈 Onwards & upwards from here!

💥 Webinar alert! 💥 Eating disorders and pregnancy Tuesday 2.5.23 2000-2130 All welcome! Link via webinar page on our website or below. We are joined by....
📔📘New book alert!📖🖋 How exciting, it is now available! I enjoyed writing this with you @KrupaBhalsod @rebeccavscott @Harryalgibson @OUPMedicine #ObstetricMedicine #CaseHistories global.oup.com/academic/produ…

🎄🎄🎄🎄🎄🎄🎄🎄🎄🎄🎄🎄 Christmas special! A Christmas Carol: Obstetric Medicine past, present and future 8th Dec 2022 1830-2015 All welcome! obstetricmedic.org.uk to register Recording available for 4 wks after live event. Then on members sectn of website 🎅🎄🤶🎁🎄

Something exciting is on the horizon... due date March 2023 (ish) @KrupaBhalsod @rebeccavscott @Harryalgibson @OUPMedicine #ObstetricMedicine #CaseHistories global.oup.com/academic/produ…

And that's a wrap from us! Thanks to all our fantastic speakers and delegates, and to @BMFMSNews for such a wonderful joint conference. #BMFMS2022 #MOMS2022 @LucyMackillop @kt2morris

It’s nearly here!! Join us in #Hobart for 2022 SOMANZ ASM this week. somanzasm.org Looking forward to an excellent line up of talks by an amazing group of people. @SOM_ANZ @OBMedicine
⭐⭐⭐⭐⭐⭐⭐⭐⭐ Next webinar! 18th October 2022 7.30-9pm BST Hypertension in pregnancy @kate_duhig #JennyMyers @l_ormesher #NatalieBarry Please register via our webinar page or via link below. All welcome, please tell your friends! 🤰🤱👶 🌟🌟🌟🌟🌟🌟🌟🌟🌟

📣 𝗦𝗔𝗩𝗘 𝗧𝗛𝗘 𝗗𝗔𝗧𝗘, #NephTwitter! We are delighted to invite you to our next Twitter Space on Pregnancy and Kidney Disease, with @kidneydoc101, @shilpa_jes, and Vincent Lee, moderated by @sibgokcay, @myadla, and hosted by ISN @FerArceAmare.
Our next LOMG meeting takes place this Wednesday 14/09/22 at 18:00 BST • Cases from SEL maternal medicine network • • Virtual meeting format as previously • @LizemarieWium @nelson_piercy @anitaobsmed @NickKametas @sadiabhatti2 Oseme Etomi Kenga Sivarajah
New online! “Haematinic deficiency in pregnancy: another HELLP mimic” by @drlaurengreen @obstetricmedic et al journals.sagepub.com/doi/full/10.11…
🏴❣️save the date❣️🏴 Scottish Adult Congenital Cardiac Conference 25th November @GJCHotel #ACHD

Peer review: a 🧵 @StephenLap and I have learnt a lot since starting as EICs of @OBMedicine and we thought it might be useful to share our thoughts and observations! Firstly: to all our reviewers, you are superheroes 🦸🦹! We recognise the time commitment so a big THANK YOU /1
@NPEU_CTU @MFH_Research are still looking for obstetricians, obstetric physicians and rhumatologists to contribute to this survey about #biologics in #pregnancy to inform pregnancy research @Marianfknight @obstetricmedic @LucyMackillop @anitaobsmed @M0MSuk
Do you care for women who are pregnant or planning a #pregnancy on #biologics? @npeu_ctu @MFH_Research want to learn about use of #biologics in pregnancy for rheumatic disorders, to inform design of an RCT. Survey here: surveys.npeu.ox.ac.uk/index.php/6528…
Do you care for women who are pregnant or planning a #pregnancy on #biologics? @npeu_ctu @MFH_Research want to learn about use of #biologics in pregnancy for rheumatic disorders, to inform design of an RCT. Survey here: surveys.npeu.ox.ac.uk/index.php/6528…
💥Next webinar 💥 Haematological conditions in pregnancy 20th June 2022 8pm-9.30pm (BST) All welcome! Link to register is on the news page of our website obstetricmedic.org.uk
We'd love to hear what you want from #ObstetricMedicine podcasts. Start a conversation!
Big news! 🔊📻🎙️ #ObstetricMedicine podcasts are coming... July 2022. Watch this space. Tell your friends. Meet the team.
🌟🌟🌟🌟Webinar alert! 🌟🌟🌟🌟 Exercise in pregnancy: can there be too much of a good thing? Tuesday 29.3.22 1930-2100 (BST) Excellent line up, including @ExercisePreg @FosteratBristol and #DrAmalHassan All welcome! Please tell your friends. Link on our website or ⬇️

New online: "Considerations for women with COVID-19 admitted to hospital" by @obstetricmedic & @FelicityCoad Open access for the next month! journals.sagepub.com/doi/full/10.11…
United States Trends
- 1. Christmas 2.89M posts
- 2. Spurs 45K posts
- 3. Knicks 30.6K posts
- 4. Cavs 18.8K posts
- 5. Wemby 22K posts
- 6. Cowboys 24.8K posts
- 7. Caruso 3,836 posts
- 8. Thunder 25.1K posts
- 9. Chet 10.2K posts
- 10. Tyler Kolek 10.6K posts
- 11. #NFLonNetflix 8,941 posts
- 12. Donovan Mitchell 8,237 posts
- 13. Brunson 12.5K posts
- 14. #NBAXmas 13.5K posts
- 15. Shai 9,863 posts
- 16. Ceedee 4,121 posts
- 17. Dylan Harper 2,131 posts
- 18. #DETvsMIN N/A
- 19. #Skol 1,161 posts
- 20. Javonte Williams 3,431 posts
You might like
Something went wrong.
Something went wrong.













































































































































